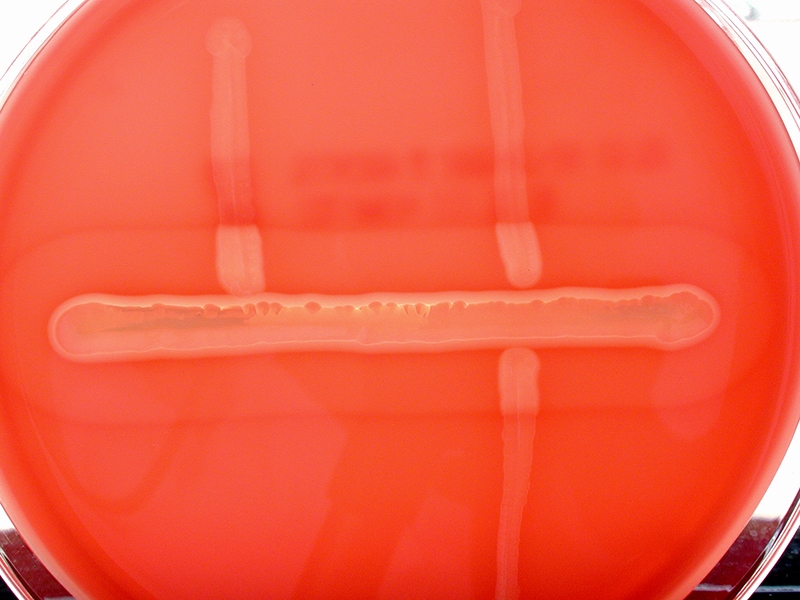

Methylene Blue stain
♦ Methylene Blue stain Or Loefflers stain is a multipurpose stain recommended for use in staining bacteria and leukocytes.. ♦ Summary Methylene Blue is recognized as a simple stain used for determining bacterial morphology. Is recommended for use in the staining of gram-negative bacteria found in spinal fluid, namely Neisseria meningitidis and Haemophilus influenzae. This tecnique, more so than gram stain, allows for better contrast these gram-negative organisms and the background. M…


.jpg)

.jpg)





.jpg)

